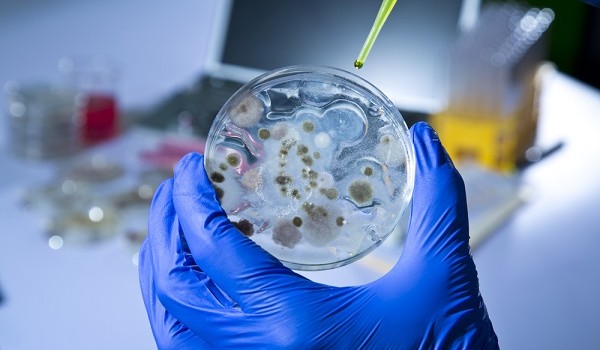

Tag: batteri
Scoperti batteri resistenti ai farmaci
Scoperta una famiglia di batteri altamente resistenti ai farmaci, in grado di diffondersi in modo più ampio – e furtivo – del previsto. Lo rivela…

Campi in erba sintetica focolaio di batteri. Allarme dei ricercatori
Presenza di Escherichia coli, di stafilococchi e di carica batterica aerobia totale sui campi in erba sintetica degli impianti sportivi (campi di calcio, calcetto, tennis)…

Aperitivi ‘batterici’, attenzione agli snack
Al via gli aperitivi sulla spiaggia a suon di bevande alcoliche o meno, ma soprattutto dei più diversi snack. Molto in voga le salse millegusti…

I batteri giusti per vivere più di cent’anni
Uno studio guidato da ricercatori dell’Alma Mater con il contributo del Cnr ha analizzato la popolazione batterica intestinale di 24 soggetti di età compresa tra…

Dormire senza mutande fa bene alla salute
Camicia da notte, t-shirt, ma niente mutande quando si va a dormire. Sia per gli uomini che per le donne è meglio evitare di indossare…

L’intestino umano? Si è adattato a inquinanti e antibiotici
Uno studio pubblicato su Current Biology al quale ha partecipato anche l’Itb-Cnr di Segrate (Mi) ha confrontato le nostre popolazioni intestinali con quelle degli Hadza,…

Allarmante aumento dei batteri resistenti agli antibiotici
Roma, Italia. La WAAAR, organizzazione no profit, supportata da 140 società in rappresentanza di medici, veterinari, chirurghi, infettivologi, farmacisti, infermieri, biologi, ecologisti, ambientalisti, provenienti da…









Devi effettuare l'accesso per postare un commento.